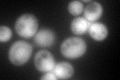
YDR510W
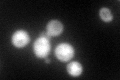
YDR510W

View description
Ubiquitin-like protein of the SUMO family, conjugated to lysine residues of target proteins; regulates chromatid cohesion, chromosome segregation, APC-mediated proteolysis, DNA replication and septin ring dynamics; phosphorylated at Ser2
Localization:
Intensity:
Fold change:
Significance:
-
C’ GFP library in SD
cytosol149.56 -
N' NOP1pr-GFP in SD

nucleus,nucleolus251.268 -
N' TEF2pr-mCherry in SD

nucleus396.822 -
N' NATIVEpr-GFP in SD

nucleus121.635 -
N' TEF2pr-VC and Cyto-VN in SD

nucleus88.0197 -
C’ GFP library in SD+DTT

cytosol241.921.61Yes -
C’ GFP library in SD+H2O2
cytosol132.820.88No -
C’ GFP library in Starvation Media

cytosol112.540.75No -
C’ GFP library on the background of Pup2-DaMP

cytosol -
C’ GFP library on the background of CCT mutant

cytosol123.8320.827956No
